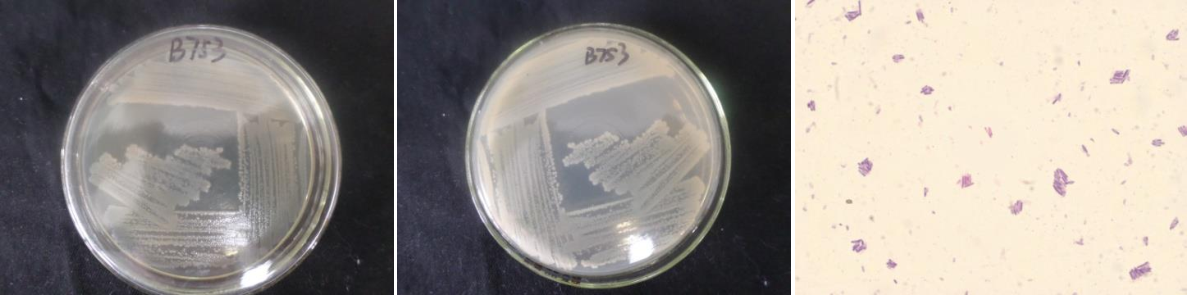

Loading...
| StrainNO | B753 |
| Classification | Bacillus |
| 16s rDNA sequence | GTGCCTAATACATGCAAGTCGAGCGAATCTGAGGGAGCTTGCTCCCAAAGATTAGCGGCGGACGGGTGAGTAACACGTGGGTAA CCTGCCTGTAAGATTGGGATAACTCCGGGAAACCGGAGCTAATACCGGATAATATTTTGAACCGCATGGTTCAAAATTGAAAGA CGGCTTTTGCTGTCACTTACAGATGGACCCGCGGCGCATTAGCTAGTTGGTGAGGTAACGGCTCACCAAGGCAACGATGCGTAG CCGACCTGAGAGGGTGATCGGCCACACTGGGACTGAGACACGGCCCAGACTCCTACGGGAGGCAGCAGTAGGGAATCTTCCGCA ATGGACGAAAGTCTGACGGAGCAACGCCGCGTGAACGATGAAGGCCTTCGGGTCGTAAAGTTCTGTTGTTAGGGAAGAACAAGT ACCAGAGTAACTGCTGGTACCTTGACGGTACCTAACCAGAAAGCCACGGCTAACTACGTGCCAGCAGCCGCGGTAATACGTAGG TGGCAAGCGTTGTCCGGAATTATTGGGCGTAAAGCGCGCGCAGGCGGTTTCTTAAGTCTGATGTGAAAGCCCACGGCTCAACCG TGGAGGGTCATTGGAAACTGGGGAACTTGAGTGCAGAAGAGGAGAGTGGAATTCCACGTGTAGCGGTGAAATGCGTAGAGATGT GGAGGAACACCAGTGGCGAAGGCGACTCTCTGGTCTGTAACTGACGCTGAGGCGCGAAAGCGTGGGGAGCGAACAGGATTAGAT ACCCTGGTAGTCCACGCCGTAAACGATGAGTGCTAAGTGTTAGAGGGTTTCCGCCCTTTAGTGCTGCAGCAAACGCATTAAGCA CTCCGCCTGGGGAGTACGGTCGCAAGACTGAAACTCAAAGGAATTGACGGGGGCCCGCACAAGCGGTGGAGCATGTGGTTTAAT TCGAAGCAACGCGAAGAACCTTACCAGGTCTTGACATCCTTCGCTACTTCTAGAGATAGAAGGTTCCCCTTCGGGGGACGAAGT GACAGGTGGTGCATGGTTGTCGTCAGCTCGTGTCGTGAGATGTTGGGTTAAGTCCCGCAACGAGCGCAACCCTTGATCTTAGTT GCCAGCATTCAGTTGGGCACTCTAAGGTGACTGCCGGTGACAAACCGGAGGAAGGTGGGGATGACGTCAAATCATCATGCCCCTTATGACCTGGGCTACACACGTGCTACAATGGATGGTACAAAGGGCTGCAAGACTGCGAAGTCAAGCGAATCCCATAAAACCATT CTCAGTTCGGATTGCAGGCTGCAACTCGCCTGCATGAAGCCGGAATCGCTAGTAATCGCGGATCAGCATGCCGCGGTGAATACG TTCCCGGGCCTTGTACACACCGCCCGTCACACCACGAGAGTTTGTAACACCCGAAGTCGGTGGGGTAACCGTAAGGAGCCAGCC GCCTAAG |
| Strain Morphology Photos | |
| Morphological Description | The morphology of Colony round;clam white;edge serrated;flat;wrinkled;slippy;sticky;waxy;The morphology of strain:Rod;having spore;terminal spore |